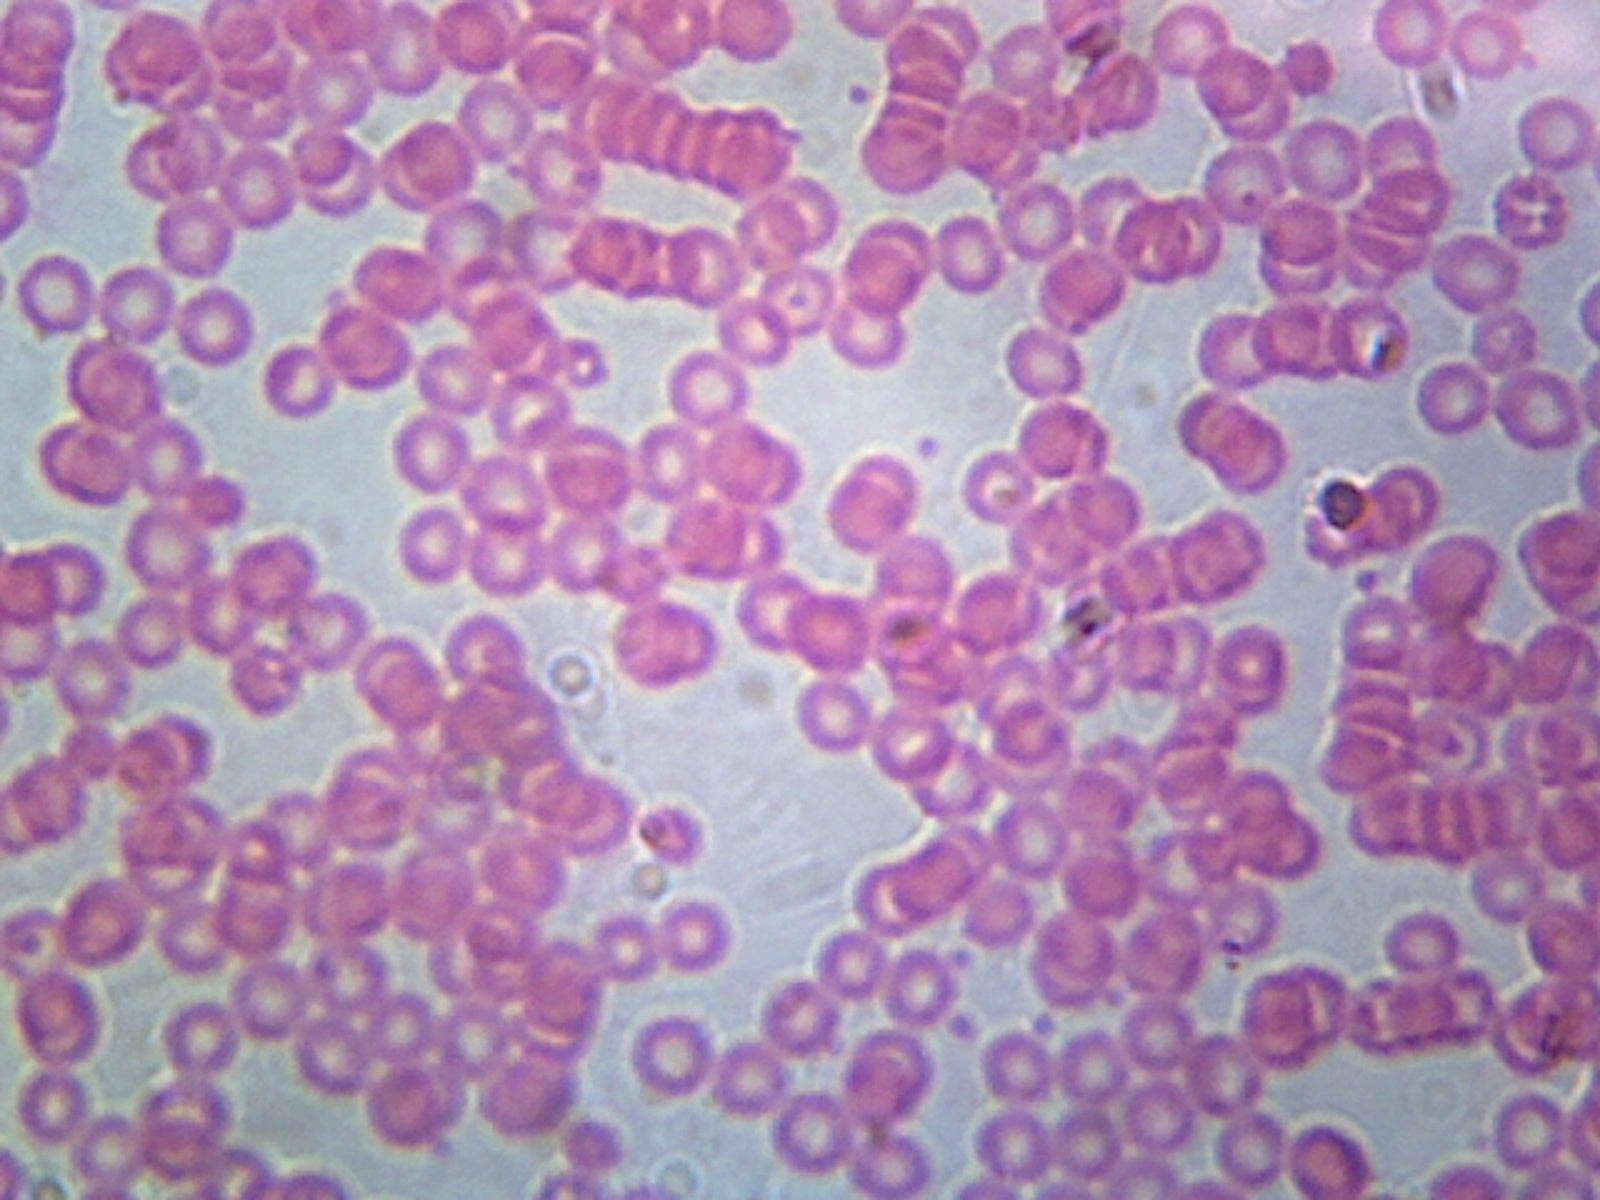
Human Blood; Smear; H&E Stain by Go Science Crazy

Description
GSC International PS0128
Histology is the branch of biology dealing with the study of organic tissues, especially on the microscopic level.
This slide is an H&E stained smear of human blood.
PRODUCT WARNINGS
This product is NOT A TOY. It is designed for educational, scientific, or professional use only. Adult supervision is required at all times. Improper use may cause injury or damage. Always follow safety guidelines and wear appropriate protective equipment. Not suitable for children 15 and under.
Certified Women's Business Enterprise
Certified Women’s Business Enterprise (WBE)
Payment & Security
Your payment information is processed securely. We do not store credit card details nor have access to your credit card information.
WHY GSC GO SCIENCE CRAZY ?

Power Up Your Science Experiments
Explore circuits, current, and magnetism with easy-to-use, reliable tools.
Shop NowFrequently Asked Questions
Shipping
Yes! We offer fast, free shipping on eligible orders within the United States.
Most orders are processed within 1–2 business days. Delivery typically takes 3–7 business days, depending on your location.
At this time, we primarily ship within the United States. For international orders, please contact our support team for assistance.
Product
Yes. Our labware and science kits are specifically designed for educational use and are trusted by schools, teachers, and homeschooling families.
Most of our kits include easy-to-follow instructions or experiment guides. If you need additional help, our support team is happy to assist.
We carry a wide range of science education tools across multiple disciplines, including:
- Labware
- Electricity and Magnetism
- Force and Motion
- Light and Sound
- Properties of Matter
- Biology
- Chemistry
- Earth Science
- Novelty Items
Our products are designed with education and safety in mind. Adult supervision is recommended for younger users, especially during experiments.
Other
We’ve been supporting science education for over 60 years, providing reliable labware and hands-on learning tools.
We accept all major credit cards and secure payment options such as Shopify Payments, PayPal, and more.
Yes! We offer a satisfaction guarantee. If you’re not fully happy with your purchase, we make returns easy.
Our friendly support team is always ready to help. Reach out via our Contact Us page or email for expert assistance.